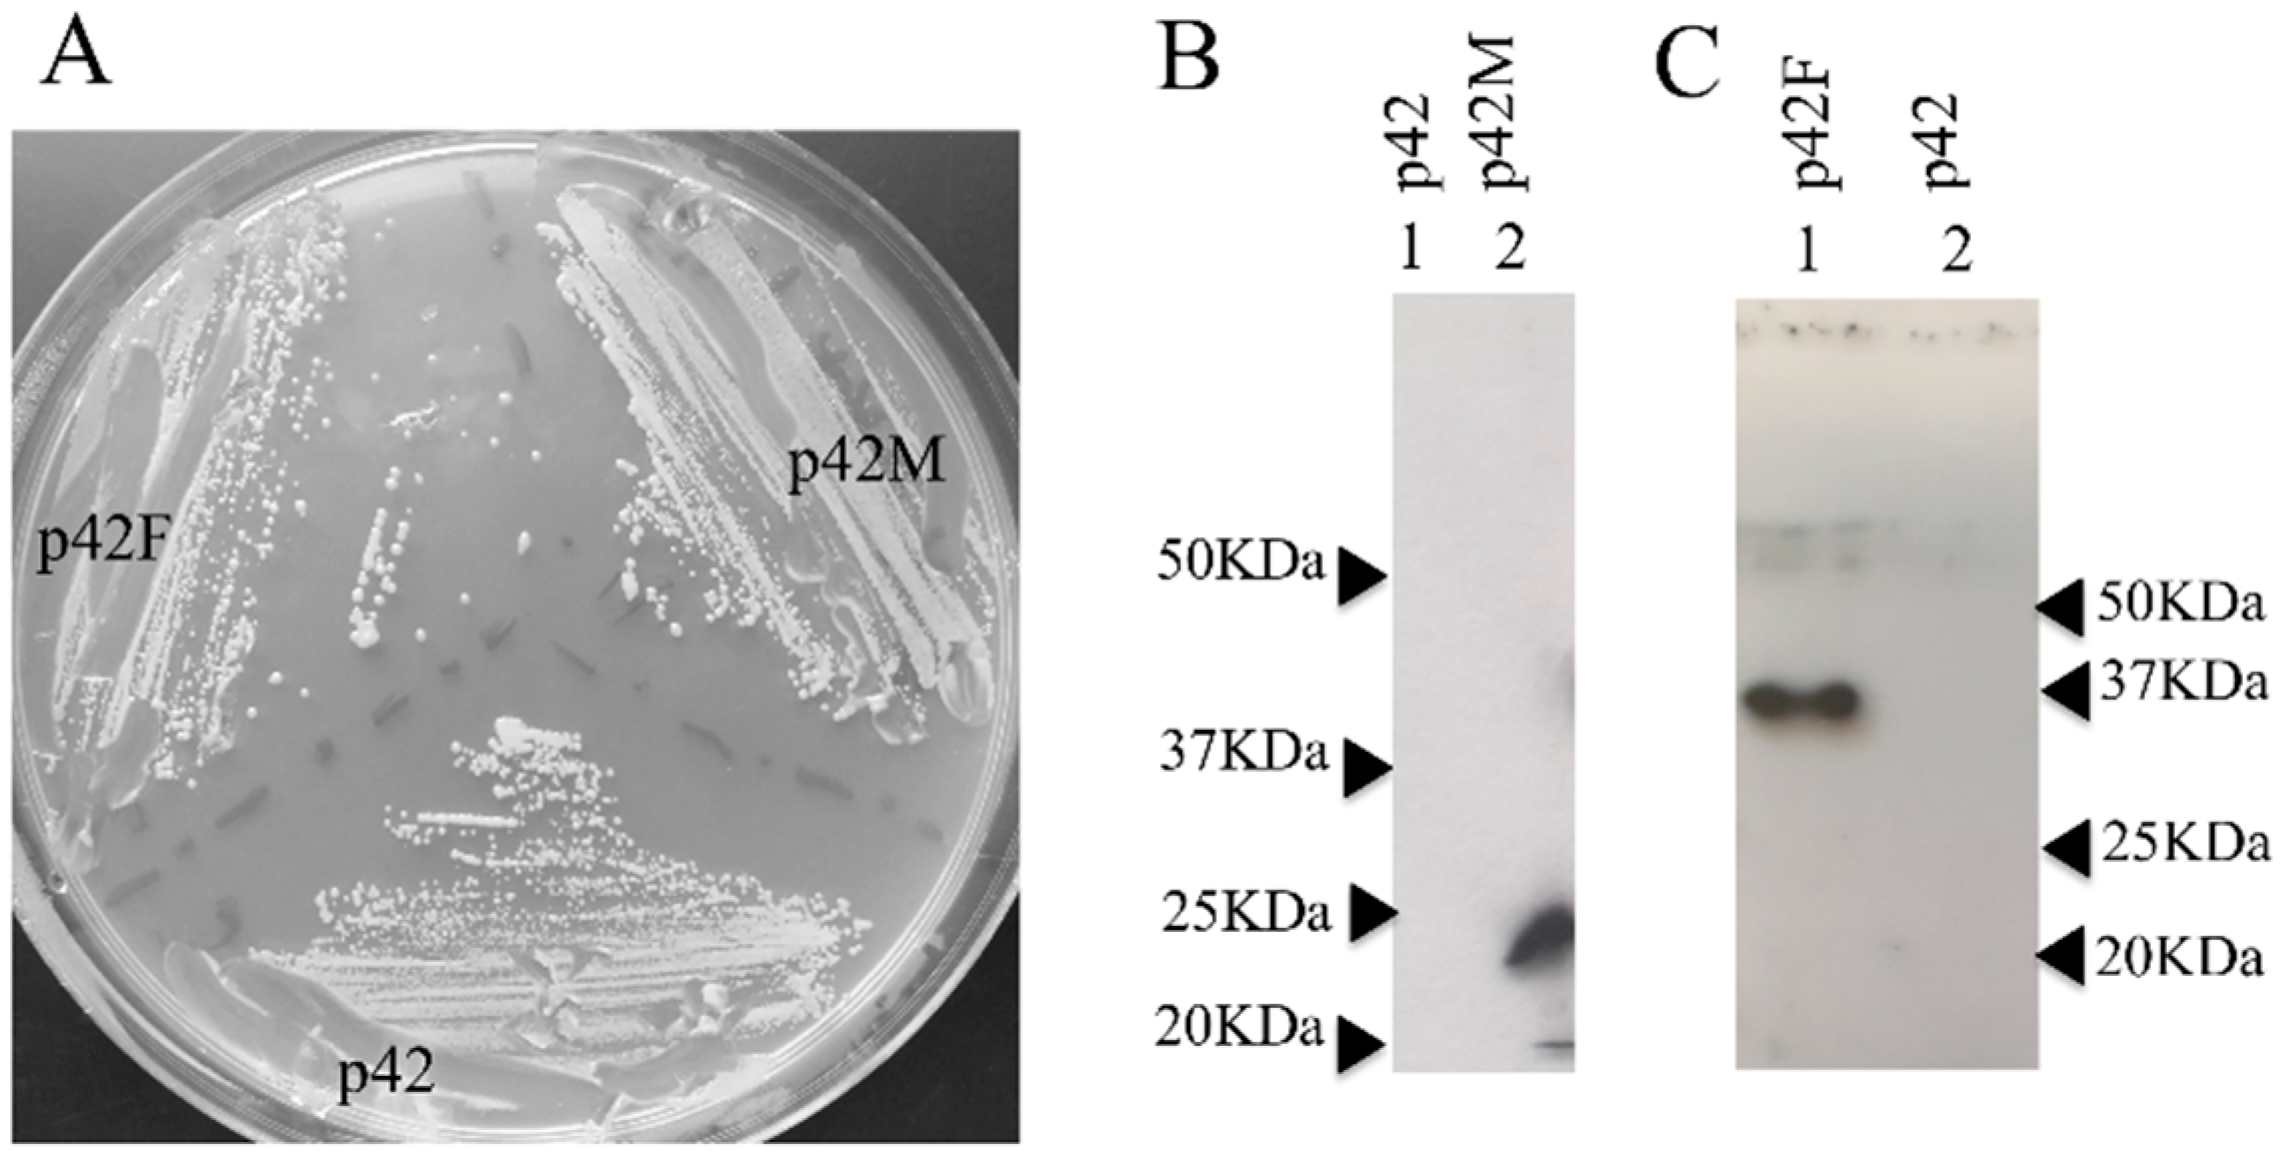
Jof 07 01069 g002 Jof 07 01069 g002

Archaeal tRNA-Splicing Endonuclease as an Effector for RNA Recombination and Novel Trans-Splicing Pathways in Eukaryotes
Abstract
1. Introduction
2. Materials and Methods
2.1. tRNA-Splicing Endonuclease Purification
2.2. RNA Synthesis In Vitro and RNA Cleavage Reactions
2.3. SCHPO Strains and Media
2.4. Vector Construction
2.5. Preparation of Cell Extracts and Western Blots
2.6. Motif Search for a Hairpin Loop
2.7. β-Galactosidase Assay
2.8. RNA Extraction and RT PCR
3. Results
3.1. The FERAC Homolog of the tRNA-Splicing Endonuclease
3.2. The FERAC tRNA Endonuclease Can Cleave the Mini BHB Motif Substrate at 30 °C In Vitro
3.3. In Vivo Expression of FERAC tRNA Endonucleases in SCHPO
3.4. The FERAC tRNA Endonuclease Mediates RNA Trans-Recombination to Form Chimeric mRNA In Vivo
3.5. Intron Regulation of Gene Expression
4. Discussion
Author Contributions
Funding
Institutional Review Board Statement
Informed Consent Statement
Acknowledgments
Conflicts of Interest
References
- Cech, T.R. Self-splicing of group I introns. Annu. Rev. Biochem. 1990, 59, 543–568. [Google Scholar] [CrossRef] [PubMed]
- Christopher, D.A.; Hallick, R.B. Euglena gracilis chloroplast ribosomal protein operon: A new chloroplast gene for ribosomal protein L5 and description of a novel organelle intron category designated group III. Nucleic Acids Res. 1989, 17, 7591–7608. [Google Scholar] [CrossRef]
- Saldanha, R.; Mohr, G.; Belfort, M.; Lambowitz, A.M. Group I and group II introns. FASEB J. 1993, 7, 15–24. [Google Scholar] [CrossRef] [PubMed]
- Grabowski, P.J.; Seiler, S.R.; Sharp, P.A. A multicomponent complex is involved in the splicing of messenger RNA precursors. Cell 1985, 42, 345–353. [Google Scholar] [CrossRef]
- Moore, M.J.; Sharp, P.A. Evidence for two active sites in the spliceosome provided by stereochemistry of pre-mRNA splicing. Nature 1993, 365, 364–368. [Google Scholar] [CrossRef] [PubMed]
- Abelson, J.; Trotta, C.R.; Li, H. TRNA splicing. J. Biol. Chem. 1998, 273, 12685–12688. [Google Scholar] [CrossRef]
- Phizicky, E.M.; Schwartz, R.C.; Abelson, J. Saccharomyces cerevisiae tRNA ligase. Purification of the protein and isolation of the structural gene. J. Biol. Chem. 1986, 261, 2978–2986. [Google Scholar] [CrossRef]
- Phizicky, E.M.; Consaul, S.A.; Nehrke, K.W.; Abelson, J. Yeast tRNA ligase mutants are nonviable and accumulate TRNA splicing intermediates. J. Biol. Chem. 1992, 267, 4577–4582. [Google Scholar] [CrossRef]
- Trotta, C.R.; Miao, F.; Arn, E.A.; Stevens, S.W.; Ho, C.K.; Rauhut, R.; Abelson, J.N. The yeast tRNA splicing endonuclease: A tetrameric enzyme with two active site subunits homologous to the archaeal tRNA endonucleases. Cell 1997, 89, 849–858. [Google Scholar] [CrossRef]
- Cannone, J.J.; Subramanian, S.; Schnare, M.N.; Collett, J.R.; D’Souza, L.M.; Du, Y.; Feng, B.; Lin, N.; Madabusi, L.V.; Müller, K.M. The comparative RNA web (CRW) site: An online database of comparative sequence and structure information for ribosomal, intron, and other RNAs. BMC Bioinform. 2002, 3, 2. [Google Scholar] [CrossRef]
- Kjems, J.; Garrett, R.A. Novel splicing mechanism for the ribosomal RNA intron in the archaebacterium Desulfurococcus mobilis. Cell 1988, 54, 693–703. [Google Scholar] [CrossRef]
- Tocchini-Valentini, G.D.; Fruscoloni, P.; Tocchini-Valentini, G.P. Evolution of introns in the archaeal world. Proc. Natl. Acad. Sci. USA 2011, 108, 4782–4787. [Google Scholar] [CrossRef]
- Yoshinari, S.; Itoh, T.; Hallam, S.J.; DeLong, E.F.; Yokobori, S.; Yamagishi, A.; Oshima, T.; Kita, K.; Watanabe, Y. Archaeal pre-mRNA splicing: A connection to hetero-oligomeric splicing endonuclease. Biochem. Biophys. Res. Commun. 2006, 346, 1024–1032. [Google Scholar] [CrossRef]
- Marck, C.; Grosjean, H. Identification of BHB splicing motifs in intron-containing tRNAs from 18 archaea: Evolutionary implications. RNA 2003, 9, 1516–1531. [Google Scholar] [CrossRef] [PubMed]
- Thompson, L.D.; Daniels, C.J. Recognition of exon-intron boundaries by the Halobacterium volcanii tRNA intron endonuclease. J. Biol. Chem. 1990, 265, 18104–18111. [Google Scholar] [CrossRef]
- Randau, L.; Calvin, K.; Hall, M.; Yuan, J.; Podar, M.; Li, H.; Söll, D. The heteromeric Nanoarchaeum equitans splicing endonuclease cleaves noncanonical bulge-helix-bulge motifs of joined tRNA halves. Proc. Natl. Acad. Sci. USA 2005, 102, 17934–17939. [Google Scholar] [CrossRef] [PubMed]
- Tocchini-Valentini, G.D.; Fruscoloni, P.; Tocchini-Valentini, G.P. Structure, function, and evolution of the tRNA endonucleases of archaea: An example of subfunctionalization. Proc. Natl. Acad. Sci. USA 2005, 102, 8933–8938. [Google Scholar] [CrossRef]
- Tocchini-Valentini, G.D.; Fruscoloni, P.; Tocchini-Valentini, G.P. Coevolution of tRNA intron motifs and tRNA endonuclease architecture in archaea. Proc. Natl. Acad. Sci. USA 2005, 102, 15418–15422. [Google Scholar] [CrossRef]
- Schwarz, T.S.; Berkemer, S.J.; Bernhart, S.H.; Weiß, M.; Ferreira-Cerca, S.; Stadler, P.F.; Marchfelder, A. Splicing endonuclease is an important player in rRNA and tRNA maturation in archaea. Front. Microbiol. 2020, 11, 594838. [Google Scholar] [CrossRef]
- Hirata, A.; Fujishima, K.; Yamagami, R.; Kawamura, T.; Banfield, J.F.; Kanai, A.; Hori, H. X-ray structure of the fourth type of archaeal tRNA splicing endonuclease: Insights into the evolution of a novel three-unit composition and a unique loop involved in broad substrate specificity. Nucleic Acids Res. 2012, 40, 10554–10566. [Google Scholar] [CrossRef]
- Li, H.; Abelson, J. Crystal structure of a dimeric archaeal splicing endonuclease. J. Mol. Biol. 2000, 302, 639–648. [Google Scholar] [CrossRef] [PubMed]
- Li, H.; Trotta, C.R.; Abelson, J. Crystal structure and evolution of a transfer RNA splicing enzyme. Science 1998, 280, 279–284. [Google Scholar] [CrossRef] [PubMed]
- Mitchell, M.; Xue, S.; Erdman, R.; Randau, L.; Söll, D.; Li, H. Crystal structure and assembly of the functional Nanoarchaeum equitans tRNA splicing endonuclease. Nucleic Acids Res. 2009, 37, 5793–5802. [Google Scholar] [CrossRef] [PubMed]
- Tocchini-Valentini, G.D.; Tocchini-Valentini, G.P. Avatar pre-tRNAs help elucidate the properties of tRNA-splicing endonucleases that produce tRNA from permuted genes. Proc. Natl. Acad. Sci. USA 2012, 109, 21325–21329. [Google Scholar] [CrossRef]
- Calvin, K.; Xue, S.; Ellis, C.; Mitchell, M.H.; Li, H. Probing the catalytic triad of an archaeal RNA splicing endonuclease. Biochemistry 2008, 47, 13659–13665. [Google Scholar] [CrossRef]
- Di Nicola Negri, E.; Fabbri, S.; Bufardeci, E.; Baldi, M.I.; Gandini Attardi, D.; Mattoccia, E.; Tocchini-Valentini, G.P. The eucaryal tRNA splicing endonuclease recognizes a tripartite set of RNA elements. Cell 1997, 89, 859–866. [Google Scholar] [CrossRef][Green Version]
- Fabbri, S.; Fruscoloni, P.; Bufardeci, E.; Di Nicola Negri, E.; Baldi, M.I.; Attardi, D.G.; Mattoccia, E.; Tocchini-Valentini, G.P. Conservation of substrate recognition mechanisms by tRNA splicing endonucleases. Science 1998, 280, 284–286. [Google Scholar] [CrossRef] [PubMed]
- Mattoccia, E.; Baldi, I.M.; Gandini-Attardi, D.; Ciafrè, S.; Tocchini-Valentini, G.P. Site selection by the tRNA splicing endonuclease of Xenopus laevis. Cell 1988, 55, 731–738. [Google Scholar] [CrossRef]
- Moreno, S.; Klar, A.; Nurse, P. Molecular genetic analysis of fission yeast Schizosaccharomyces pombe. Methods Enzymol. 1991, 194, 795–823. [Google Scholar] [CrossRef]
- Craven, R.A.; Griffiths, D.J.; Sheldrick, K.S.; Randall, R.E.; Hagan, I.M.; Carr, A.M. Vectors for the expression of tagged proteins in Schizosaccharomyces pombe. Gene 1998, 221, 59–68. [Google Scholar] [CrossRef]
- Eddy, S. RNABOB: A Program to Search for RNA Secondary Structure Motifs in Sequence Databases. 2008. Available online: http://eddylab.org/software.html (accessed on 19 November 2021).
- Forsburg, S.L. Comparison of Schizosaccharomyces pombe expression systems. Nucleic Acids Res. 1993, 21, 2955–2956. [Google Scholar] [CrossRef]
- Miller, J. A Short Course in Bacterial Genetics: A Laboratory Manual and Handbook for Escherichia coli and Related Bacteria; Cold Spring Harbor Laboratory Press: Plainview, NY, USA, 1992. [Google Scholar]
- Bond, P.L.; Druschel, G.K.; Banfield, J.F. Comparison of acid mine drainage microbial communities in physically and geochemically distinct ecosystems. Appl. Environ. Microbiol. 2000, 66, 4962–4971. [Google Scholar] [CrossRef]
- Basi, G.; Schmid, E.; Maundrell, K. TATA box mutations in the Schizosaccharomyces pombe nmt1 promoter affect transcription efficiency but not the transcription start point or thiamine repressibility. Gene 1993, 123, 131–136. [Google Scholar] [CrossRef]
- Maundrell, K. Thiamine-repressible expression vectors pREP and pRIP for fission yeast. Gene 1993, 123, 127–130. [Google Scholar] [CrossRef]
- Javerzat, J.P.; Cranston, G.; Allshire, R.C. Fission yeast genes which disrupt mitotic chromosome segregation when overexpressed. Nucleic Acids Res. 1996, 24, 4676–4683. [Google Scholar] [CrossRef]
- Fisher, C.R. Enzymology of the pigmented adenine-requiring mutants of Saccharomyces and Schizosaccharomyces. Biochem. Biophys. Res. Commun. 1969, 34, 306–310. [Google Scholar] [CrossRef]
- Haupt, I.; Thrum, H. Bacterial resistance to streptothricins. J. Basic Microbiol. 1985, 25, 335–339. [Google Scholar] [CrossRef]
- Hentges, P.; Van Driessche, B.; Tafforeau, L.; Vandenhaute, J.; Carr, A.M. Three novel antibiotic marker cassettes for gene disruption and marker switching in Schizosaccharomyces pombe. Yeast 2005, 22, 1013–1019. [Google Scholar] [CrossRef] [PubMed]
- Krügel, H.; Fiedler, G.; Smith, C.; Baumberg, S. Sequence and transcriptional analysis of the nourseothricin acetyltransferase-encoding gene nat1 from Streptomyces noursei. Gene 1993, 127, 127–131. [Google Scholar] [CrossRef]
- Deidda, G.; Rossi, N.; Tocchini-Valentini, G.P. An archaeal endoribonuclease catalyzes cis- and trans- nonspliceosomal splicing in mouse cells. Nat. Biotechnol. 2003, 21, 1499–1504. [Google Scholar] [CrossRef]
- Deidda, G.; Rossi, N.; Putti, S.; Tocchini-Valentini, G.P. ARCHAEA-ExPRESs targeting of alpha-tubulin 4 mRNA: A model for high-specificity trans-splicing. FASEB J. 2010, 24, 2976–2984. [Google Scholar] [CrossRef] [PubMed]
- Putti, S.; Calandra, P.; Rossi, N.; Scarabino, D.; Deidda, G.; Tocchini-Valentini, G.P. Highly efficient, in vivo optimized, archaeal endonuclease for controlled RNA splicing in mammalian cells. FASEB J. 2013, 27, 3466–3477. [Google Scholar] [CrossRef] [PubMed]
- Di Segni, G.; Gastaldi, S.; Tocchini-Valentini, G.P. Cis- and trans-splicing of mRNAs mediated by tRNA sequences in eukaryotic cells. Proc. Natl. Acad. Sci. USA 2008, 105, 6864–6869. [Google Scholar] [CrossRef] [PubMed]
- Zamboni, M.; Scarabino, D.; Tocchini-Valentini, G.P. Splicing of mRNA mediated by tRNA sequences in mouse cells. RNA 2009, 15, 2122–2128. [Google Scholar] [CrossRef] [PubMed][Green Version]

Publisher’s Note: MDPI stays neutral with regard to jurisdictional claims in published maps and institutional affiliations. |
© 2021 by the authors. Licensee MDPI, Basel, Switzerland. This article is an open access article distributed under the terms and conditions of the Creative Commons Attribution (CC BY) license (https://creativecommons.org/licenses/by/4.0/).
Share and Cite
Tocchini-Valentini, G.D.; Tocchini-Valentini, G.P. Archaeal tRNA-Splicing Endonuclease as an Effector for RNA Recombination and Novel Trans-Splicing Pathways in Eukaryotes. J. Fungi 2021, 7, 1069. https://doi.org/10.3390/jof7121069
Tocchini-Valentini GD, Tocchini-Valentini GP. Archaeal tRNA-Splicing Endonuclease as an Effector for RNA Recombination and Novel Trans-Splicing Pathways in Eukaryotes. Journal of Fungi. 2021; 7(12):1069. https://doi.org/10.3390/jof7121069
Chicago/Turabian StyleTocchini-Valentini, Giuseppe D., and Glauco P. Tocchini-Valentini. 2021. "Archaeal tRNA-Splicing Endonuclease as an Effector for RNA Recombination and Novel Trans-Splicing Pathways in Eukaryotes" Journal of Fungi 7, no. 12: 1069. https://doi.org/10.3390/jof7121069
APA StyleTocchini-Valentini, G. D., & Tocchini-Valentini, G. P. (2021). Archaeal tRNA-Splicing Endonuclease as an Effector for RNA Recombination and Novel Trans-Splicing Pathways in Eukaryotes. Journal of Fungi, 7(12), 1069. https://doi.org/10.3390/jof7121069





